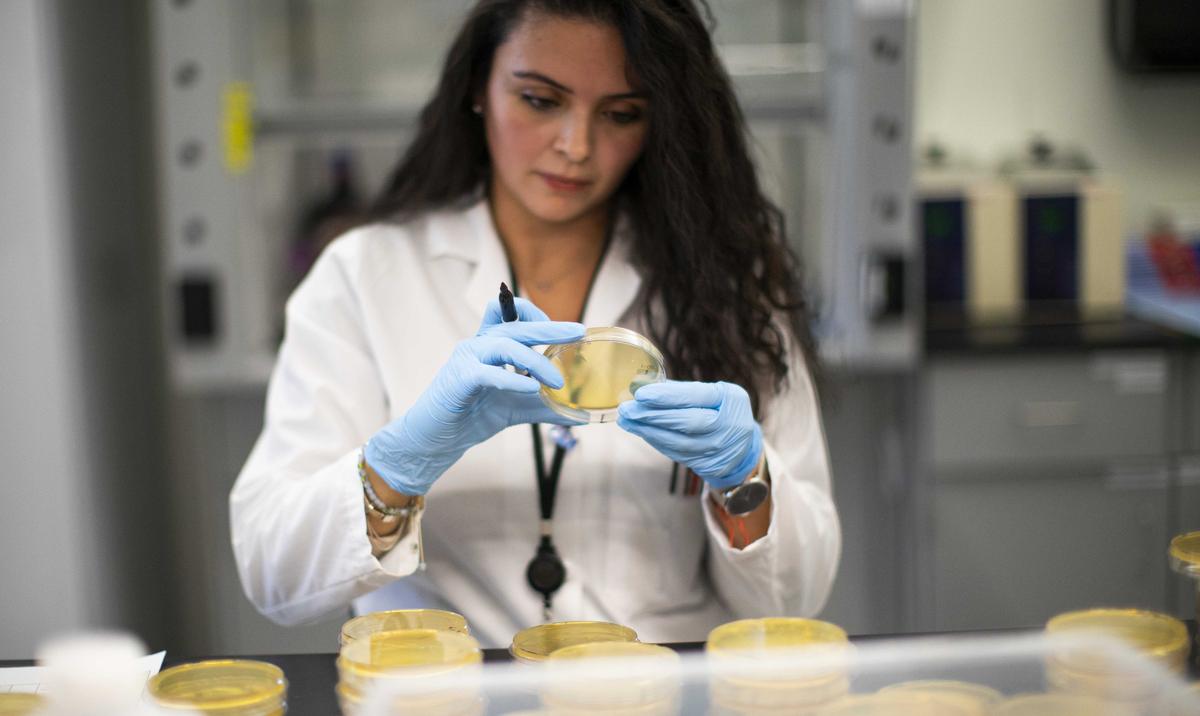
Warm Weather May Stem CCP Virus Spread, but Won’t Stop It: Study
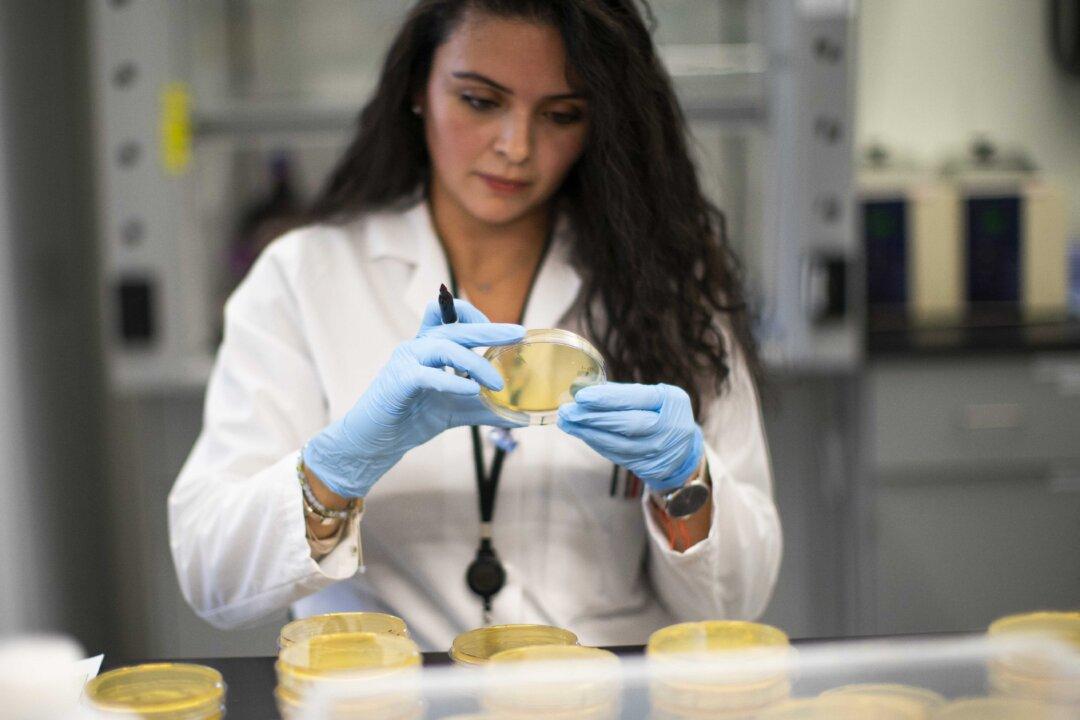
Warm Weather May Stem CCP Virus Spread, but Won’t Stop It: Study

While warmer temperatures and humid climates can’t completely eradicate the CCP virus, they may hinder its spread, new research suggests.
The March 19 study, titled “Will Coronavirus Pandemic Diminish by Summer?” was conducted by researchers at the Massachusetts Institute of Technology (MIT), and analyzes the patterns in local weather of the regions affected by COVID-19.